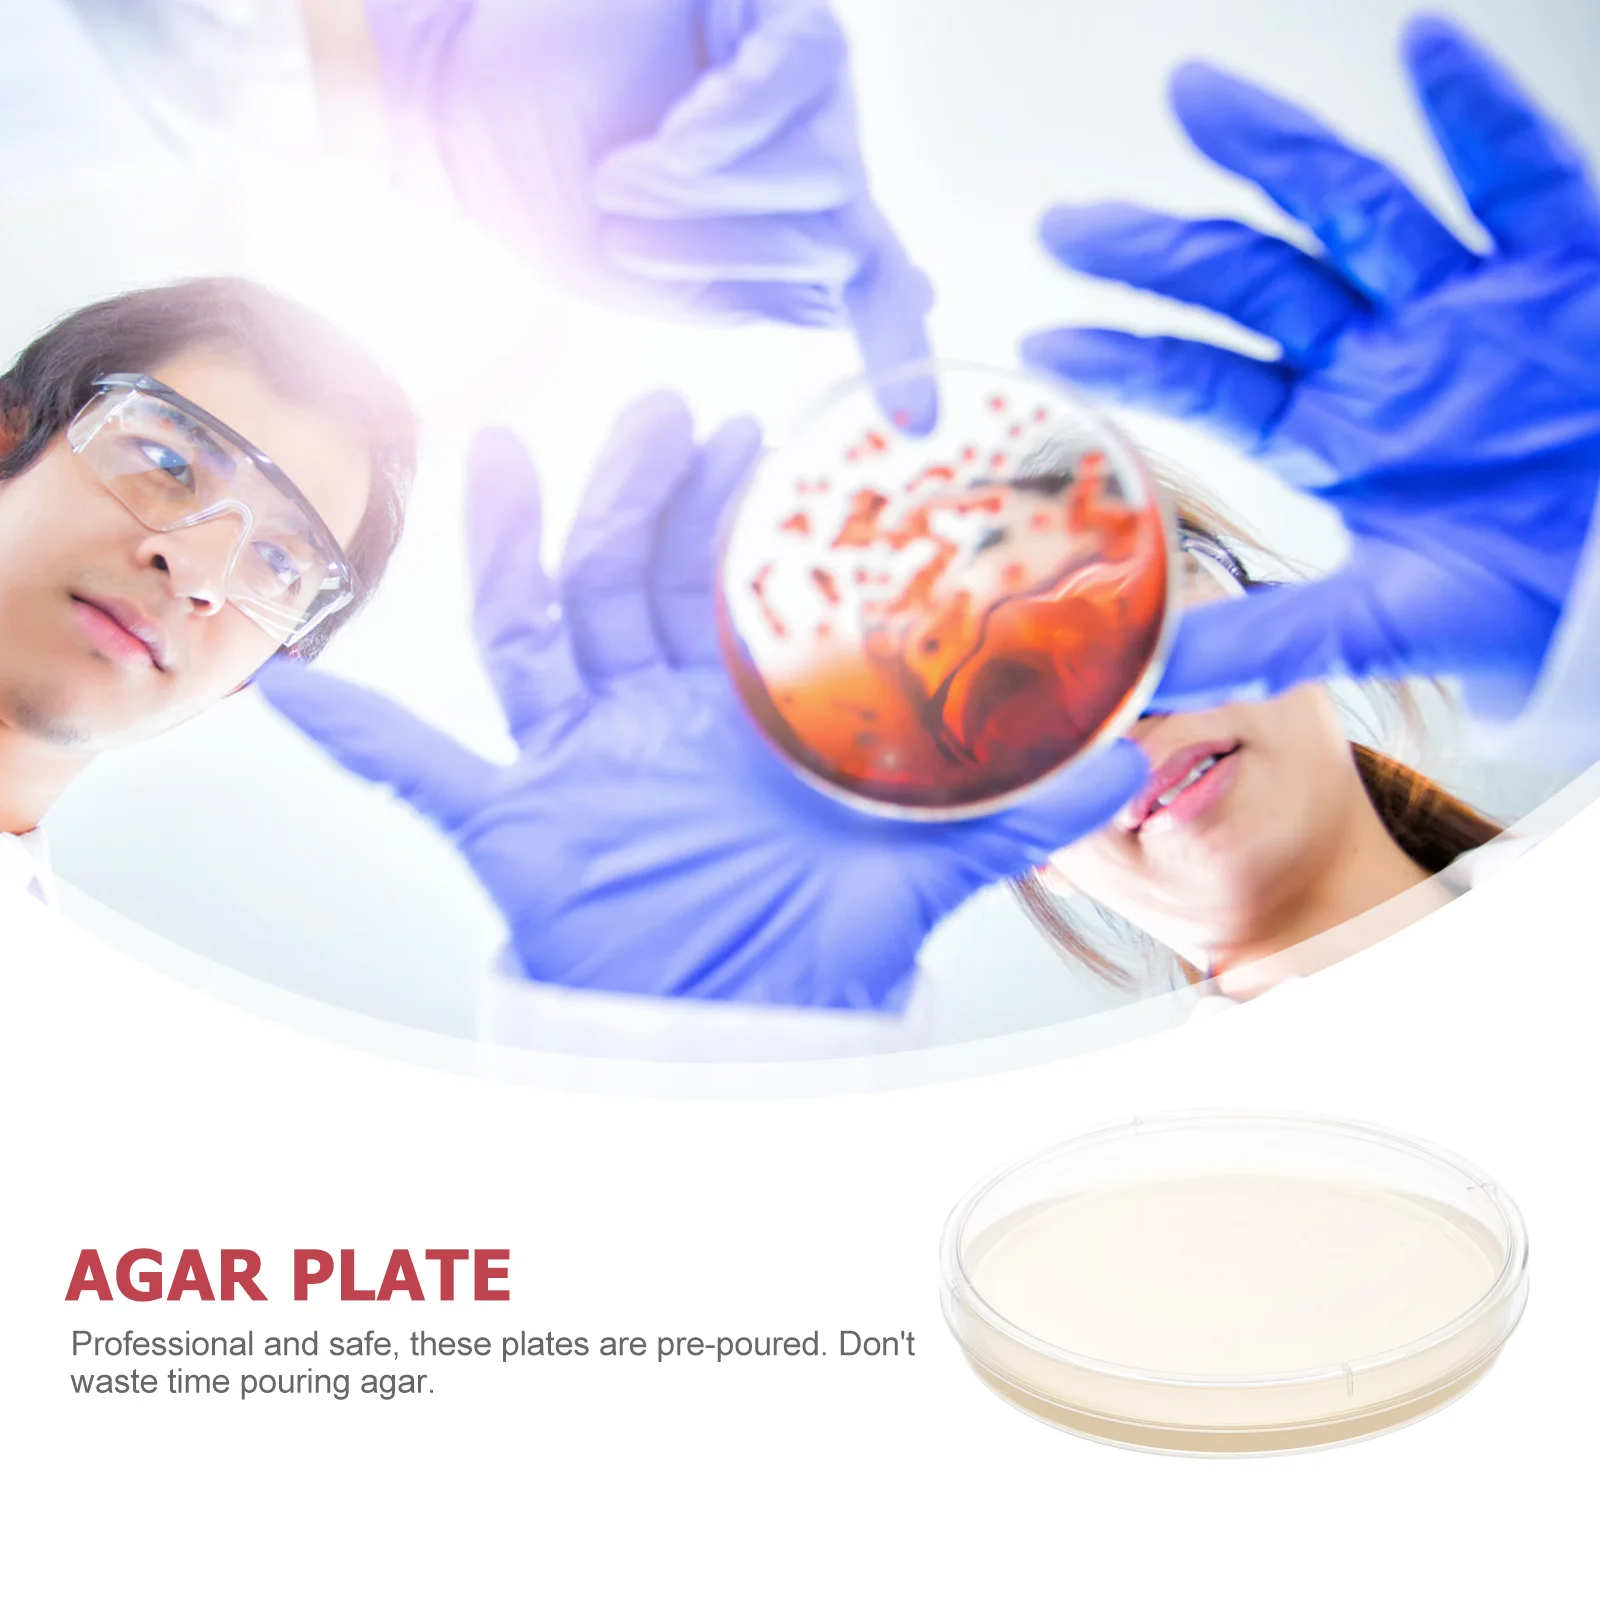
thumb

10 шт. чашки Петри с агаровыми лабораториями, Агаровые тарелки, проект по научной ярмарке, набор
Price history chart & currency exchange rate
Customers also viewed

$25.73
Насадка для душа с регулируемым вентилятором, ручной водосберегающий фильтр с одной кнопкой, насадка для ванной комнаты, экономия воды и душа
aliexpress.ru
$18.07
Новинка 2024, уличная винтажная Толстовка с вышивкой алфавита для мужчин y2k, модное пальто в готическом стиле Харадзюку, Повседневная Свободная Толстовка для пар
aliexpress.ru
$260.00
4PCS/1Set CRG069 Toner Cartridge for Canon MF752CDW Compatible Toner Powder MF756CX MF750 with Chip
aliexpress.com
$99.61
Турбинный картридж для Hyundai H-1 Starex 2,5 CRDI 125Kw D4CB 16V Turbo Chra сбалансированный Турбокомпрессор Core 28200-4A480 2007-
aliexpress.ru
$72.63
HWT Hiro World Trade Tin Signs Set of 5 American Diner Retro Vintage Interior Goods Wall Hanging (Beer)
joom.com
$71.82
Постельное белье Home me Baby Happy me Детское 70х140 Хлопок перкаль Basic Розовое
rozetka.com.ua
$0.90
1PC Bowknot Shiny Glitter Popular Cute Sequins Barrettes Hair Clips Headwear Hair Accessoires Handmade Hairpins Girls
aliexpress.com
$14.78
Main Brush Side Brush HEPA Cleaning Cloth for Ecovacs Deebot Ozmo T8 Robot Vacuum Cleaner Accessories
aliexpress.com
$13.26
New Spruce Christmas Wreath With LED Light Front Door Hanging Garland Holiday Home Product Hot
aliexpress.com
$9.60
Men's winter warm slippers Couple models Solid Colors Non-slip flat slide Home Floor high quality Soft Shoes Man footwear A40
aliexpress.com
$1.37
10/ 6/ 4/ 1PCS 220V PIR Motion Sensor Switch IR Infrared Human body Induction Sensor light Control Detector For LED Lamp or Fan
aliexpress.com
$1.55
Wall-Mounted Monitor Support No Punching Rotation 360 Degree Security Mount Easy Install Abs Material Non Drilling Wall Camera
aliexpress.ru
$32.71
ZERAINS новая осенне-зимняя женская кожаная повседневная бархатная куртка из оленьей кожи с короткими рукавами и лацканами
aliexpress.ru

-.jpg?1&s=340e336409fa234864e6deff9c873333)








